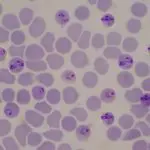
Malaria infected blood cells: Photo 214528878 © Chirawan Somsanuk | Dreamstime.com

Do you know where the freshwater eel starts and ends its life? It not only has an amazing journey but an extraordinary lifecycle. Come and see:
[Editor’s note: For more information, see fellow Creation Club contributor Richard Nelson’s article on the Eel]